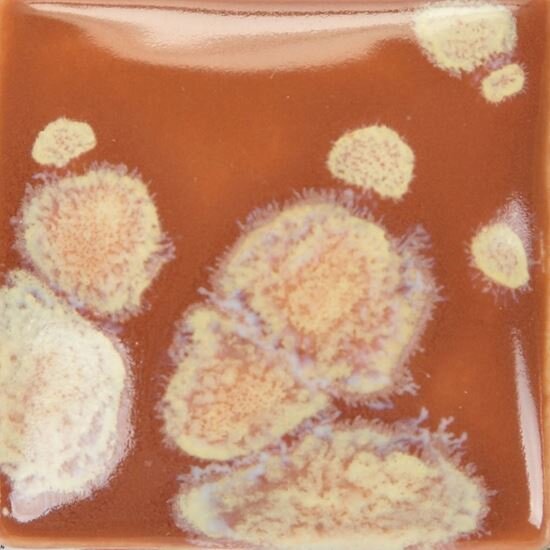

Duncan Glaze - Crystals Ancient Woodland
Regular price
Unit price
per
Tax included.
Earthenware glaze118ml tubThese unique glazes create bright, multicoloured bursts and specks when fired, resulting in a different finish every time. crystal pebbles of varying sizes...
Earthenware glaze
118ml tub
These unique glazes create bright, multicoloured bursts and specks when fired, resulting in a different finish every time. crystal pebbles of varying sizes are embedded into the glaze and burst in the kiln to reveal an explosion of multicolour flecks.
suggested firing temp 999°c to 1040°c
